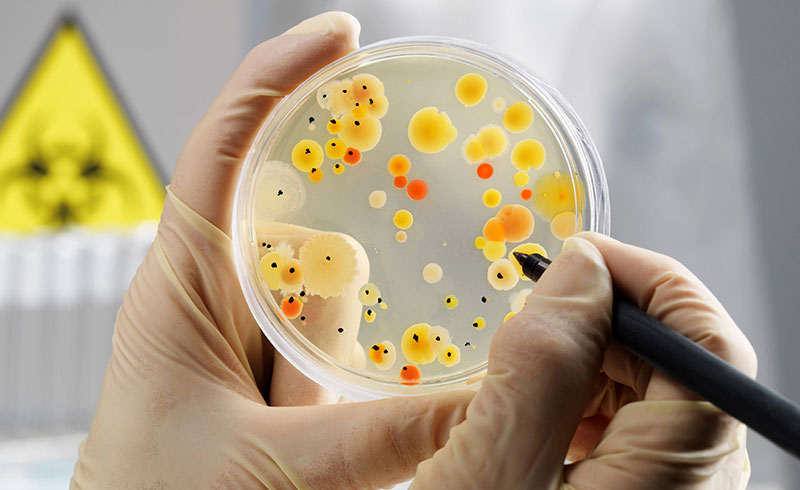

A CardioMiopatia Hipertrófica (CMH), uma doença do músculo cardíaco caracterizada por hipertrofia assimétrica ou simétrica do ventrículo esquerdo (HVE), é causa mais comum de morte súbita em idade jovem.
Saiba maisConsulte em baixo a nossa lista de Exames, Diagnósticos, Rastreios e Artigos informativos sobre os diversos temas de saúde.
Pode utilizar os filtros em baixo para o ajudar a encontrar a informação que precisa.